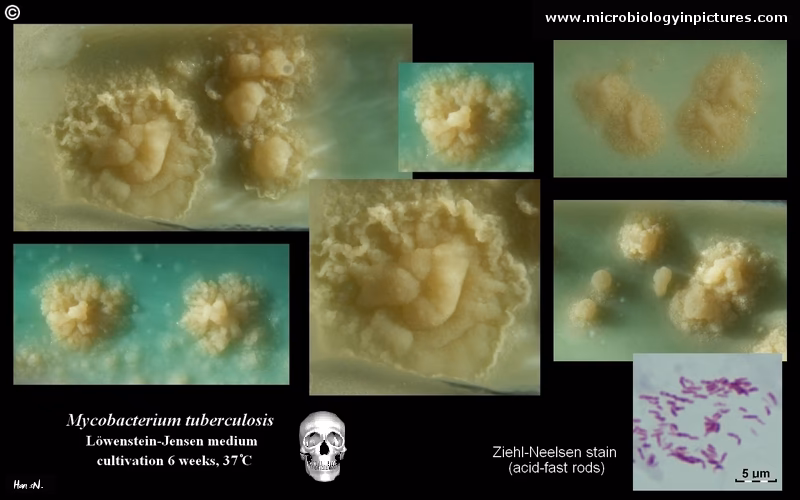
What color is Mycobacterium tuberculosis?

02/09/2017
Mycobacterium tuberculosis er en yderst patogen bakterie og den primære årsag til tuberkulose (TB) på verdensplan. Denne mikrobe inficerer hovedsageligt lungerne, men dens sande styrke ligger i dens utrolige evne til at overleve i et fjendtligt mikromiljø, hvilket endda kan føre til en livslang, sovende infektion kendt som latent tuberkulose. Når den først har etableret sig i en vært, tilpasser og modulerer Mycobacterium tuberculosis sig selv for at modstå en række ugunstige forhold og stressfaktorer, herunder sure miljøer, lavt iltindhold (hypoxi), varmestress, angreb fra immunsystemet og oxidativt stress. Dens unikke biologi, herunder en cellevæg med et højt lipidindhold, få porer og et DNA med højt GC-indhold, bidrager til dens langsomme vækstrate, hvilket giver den en fordel i at undgå værtens forsvar og overleve behandlinger.
Hvad er Mycobacterium tuberculosis?
Mycobacterium tuberculosis er en stavformet bakterie, der adskiller sig markant fra mange andre patogener. Dens langsomme vækst er en overlevelsesstrategi i sig selv. For at klare de mange udfordringer inde i værten, benytter bakterien sig af sofistikerede mekanismer. En af disse er Toxin-antitoksin (TA) systemer, som hjælper den med at modstå forskellige stressforhold. Selvom disse systemer er mere almindelige hos miljøbakterier, har M. tuberculosis udviklet sine egne for at overleve i menneskekroppen.
En central overlevelsesstrategi er dvale, eller latens. Under ugunstige forhold kan bakterien gå i en sovende tilstand, hvor den er beskyttet mod både immunsystemet og antibiotika. Proteinet DATIN (Dormancy Associated Translation Inhibitor) spiller en afgørende rolle i reguleringen af denne latente fase ved at hæmme bakteriens proteinsyntese. Når forholdene forbedres, kan bakterien genoplives, og den bliver ofte tolerant over for antibiotika ved at danne biofilm. Et andet vigtigt protein er PpiB (peptidyl-prolyl isomerase), som er involveret i dannelsen af disse biofilm og dermed medvirker til lægemiddeltolerance.
Hvordan M. tuberculosis undgår kroppens immunforsvar
Bakteriens overlevelse afhænger af dens evne til at manipulere og undvige værtens immunsystem. Den første forsvarslinje, den møder, er typisk makrofager i lungerne – immunceller designet til at opsluge og ødelægge invaderende patogener.
Undgåelse af nedbrydning i makrofager
Normalt, når en makrofag opsluger en bakterie, fusionerer den med en lysosom for at danne et fagolysosom, hvor bakterien nedbrydes. M. tuberculosis forhindrer aktivt denne fusion. Ved hjælp af molekyler som mannose-kappet lipoarabinomannan på sin overflade og udskillelse af proteiner som TB9.8 og TB10.4, saboterer den processen og skaber et sikkert levested inde i selve immuncellen.
Modstand mod stressfaktorer
Selv hvis fagolysosomet dannes, er M. tuberculosis ikke forsvarsløs. Den kan modstå det sure miljø ved hjælp af proteaser som MarP og ved at opretholde en stabil pH-balance internt. Når den står over for iltmangel (hypoxi) i nekrotiske granulomer, aktiverer den proteiner som Lsr2 og skifter sin metabolisme for at overleve. Den kan også håndtere varmestress ved at producere varmechokproteiner (Hsp). Desuden har den udviklet avancerede systemer til at håndtere metalioner. Den stjæler jern fra værten ved hjælp af sideroforer og beskytter sig mod giftige overbelastninger af zink og kobber ved hjælp af specifikke transportproteiner og metallothioneiner.
Smitte og sygdomsudvikling
M. tuberculosis spredes primært gennem luften. Når en person med aktiv lungetuberkulose hoster, nyser eller taler, frigives små dråber (aerosoler) indeholdende bakterien. Hvis en anden person indånder disse aerosoler, kan bakterierne nå de dybeste dele af lungerne, alveolerne. Her bliver de opslugt af makrofager, hvilket er det første skridt i etableringen af en infektion. Bakterien bruger specifikke adhæsionproteiner, såsom fibronectin-bindende proteiner (FnBP'er), til at binde sig til værtsceller og starte infektionsprocessen. Selvom den primære indgangsport er makrofager, kan den også trænge ind via epitelceller.

De Forskellige Faser af Tuberkulose
Efter den første eksponering kan infektionen udvikle sig i to hovedretninger: latent infektion eller aktiv sygdom. WHO estimerede, at der i 2019 var over 10 millioner tilfælde af tuberkulose og 1,4 millioner dødsfald, hvilket understreger sygdommens alvor.
Latent Tuberkuloseinfektion (LTBI)
I de fleste tilfælde (omkring 90-95%) formår immunsystemet at indkapsle bakterierne i små knuder kaldet granulomer. Inden i disse granulomer er bakterierne i en sovende, metabolisk inaktiv tilstand. En person med LTBI er ikke syg, har ingen symptomer og kan ikke smitte andre. Bakterierne er dog stadig i live, og infektionen kan reaktiveres senere i livet, især hvis immunforsvaret svækkes. Risikoen for reaktivering er omkring 5-15% over en livstid.
Aktiv Tuberkulose (aTB)
Hvis immunsystemet ikke kan kontrollere den oprindelige infektion, eller hvis en latent infektion reaktiveres, begynder bakterierne at formere sig aktivt. Dette fører til aktiv tuberkulose, som er en alvorlig og smitsom sygdom. Symptomerne udvikler sig gradvist og kan omfatte en vedvarende hoste (ofte med blodigt opspyt), feber, nattesved, vægttab, træthed og brystsmerter.
Sammenligning af Latent og Aktiv Tuberkulose
| Egenskab | Latent TB (LTBI) | Aktiv TB (aTB) |
|---|---|---|
| Bakteriestatus | Inaktive, men levende (sovende) | Aktive, formerer sig i kroppen |
| Symptomer | Ingen symptomer, føler sig ikke syg | Hoste, feber, vægttab, nattesved |
| Smitsomhed | Kan ikke smitte andre | Kan smitte andre gennem luften |
| Røntgen af brystet | Typisk normalt | Ofte unormalt (f.eks. infiltrater, kaverner) |
| Immuntest (hudtest/blodprøve) | Positiv | Positiv |
Forskellige Typer af Tuberkulose
Selvom tuberkulose oftest forbindes med lungerne, kan sygdommen påvirke næsten alle dele af kroppen. Dette kaldes ekstrapulmonal tuberkulose.
Lungetuberkulose
Dette er den mest almindelige form for TB, hvor infektionen er begrænset til lungerne. Det er også den primære form, der er smitsom. Symptomerne er de klassiske, som nævnt ovenfor.
Miliær Tuberkulose
En sjælden, men yderst alvorlig form, hvor bakterierne spredes massivt via blodbanen og danner små, hirse-lignende læsioner i mange organer samtidigt, herunder lever, milt, knoglemarv og hjernehinder. Symptomerne er ofte uspecifikke som feber og vægttab, hvilket kan gøre diagnosen vanskelig.

Tuberkuløse Kaverner
Ved fremskreden lungetuberkulose kan immunforsvarets reaktion føre til ødelæggelse af lungevæv, hvilket skaber hulrum kaldet kaverner. Disse kaverner er iltrige miljøer, hvor bakterierne trives og formerer sig i enorme mængder. Personer med kaverner er ekstremt smitsomme og har en højere risiko for behandlingssvigt og tilbagefald.
Hudtuberkulose (Kutan Tuberkulose)
En sjælden manifestation, hvor TB-bakterien inficerer huden. Dette kan ske ved direkte kontakt, spredning fra et nærliggende infektionsfokus (f.eks. en lymfeknude) eller via blodet. Det kan vise sig som sår, knuder eller bylder og kan ligne mange andre hudsygdomme.
Neurologisk Tuberkulose
Dette er en af de mest alvorlige former for ekstrapulmonal TB, hvor infektionen påvirker centralnervesystemet. Det kan føre til tuberkuløs meningitis (hjernehindebetændelse), tuberkulomer (tumorer-lignende masser i hjernen) eller infektion i rygmarven. Symptomerne udvikler sig fra vage tegn som hovedpine og træthed til alvorlige neurologiske udfald som kramper, lammelser og koma.
Ofte Stillede Spørgsmål (FAQ)
Er Mycobacterium tuberculosis multiresistent?
Ikke alle stammer af M. tuberculosis er multiresistente, men bakteriens iboende overlevelsesmekanismer, såsom dvaletilstand og biofilm-dannelse, gør den naturligt tolerant over for mange stressfaktorer, herunder antibiotika. Multiresistent tuberkulose (MDR-TB) er en specifik form, hvor bakterien har udviklet resistens mod de to mest effektive førstelinje-antibiotika (isoniazid og rifampicin). Dette er et voksende globalt sundhedsproblem, der kræver længere, dyrere og mere giftige behandlingsforløb.
Hvilken farve har Mycobacterium tuberculosis?
Bakterien i sig selv har ikke en farve, der er synlig for det blotte øje. I laboratoriet identificeres den ved hjælp af en speciel farvningsmetode kaldet Ziehl-Neelsen-farvning. På grund af sin unikke, voksagtige cellevæg holder den fast på den røde farve (karbolfuksin), selv efter at være blevet vasket med syre. Dette får den til at fremstå som klare røde eller pink stave mod en blå baggrund under mikroskopet. Denne egenskab er grunden til, at den kaldes en syrefast stav.
Hvad er forskellen på latent og aktiv tuberkulose?
Den primære forskel ligger i bakteriens aktivitet og kroppens reaktion. Ved latent TB er bakterierne i dvale, indkapslet af immunsystemet, og personen har ingen symptomer og er ikke smitsom. Ved aktiv TB formerer bakterierne sig, forårsager vævsskade, og personen er syg og kan smitte andre. En latent infektion kan dog udvikle sig til en aktiv sygdom, hvis immunforsvaret svækkes.
Hvis du vil læse andre artikler, der ligner Mycobacterium tuberculosis: En Dybdegående Guide, kan du besøge kategorien Sygdom.

